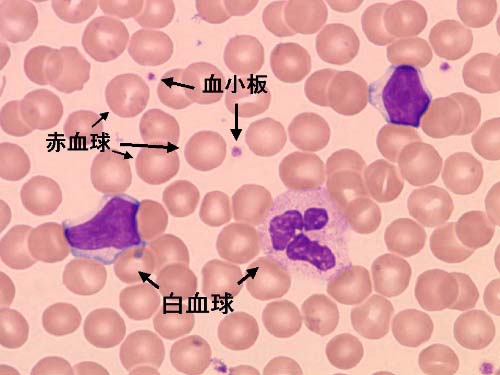

本文
臨床検査とは
ご存知ですか、臨床検査
臨床検査とは
人体から排出される尿、便、人体を流れている血液、髄液や人体を作っている細胞、臓器などを検査する検体検査と、臓器の状態を物理的に捉らえる生理機能検査などがあります。臨床検査は病気の診断、治療、病気の早期発見や予防になくてはならない手段です。
1.一般検査(尿・便)
(1)尿検査
尿検査で身体の状態がよく分かります。
健康な人の尿には、タンパクや糖などほとんど見られません。
尿を調べると腎臓、膀胱、肝臓の病気まで見つけることができます。
また膀胱炎などの感染症の診断、時には悪性腫瘍の情報も得られます。


(2)便検査
便潜血反応
便の中に血液が混ざっているかどうかを調べる検査です。消化管内の出血の有無を調べることで、潰瘍やポリープ、癌などを間接的に調べることができます。
寄生虫検査
回虫、鞭中、条虫などの虫体やこれらの虫卵を調べます。

回虫卵(60×50ミクロン)

鞭虫卵(50×25ミクロン)

条虫卵(40×30ミクロン)
2.血液検査
血液は酸素や栄養素を各組織や細胞に運ぶと共に、二酸化炭素や老廃物を運び出す働きをしています。
大きさ:白血球(10~20ミクロン)、赤血球(7~8ミクロン)、血小板(4~5ミクロン)
赤血球数検査
赤血球が減ると運ばれる酸素の量が足りなくなり、貧血が起こります。増えすぎると、血液が濃くなって流れにくくなり、血管がつまりやすくなります。
ヘモグロビン(血色素)値の検査
ヘモグロビン(血色素)は赤血球の主成分で酸素や二酸化炭素を運びます。
白血球数検査
体内に細菌や異物が侵入して炎症を起こすと、白血球が増加します。
血小板数検査
血管が損傷されて出血した場合、血小板は止血するのに重要な役割をします。血小板が減少したり、機能が低下すると、血が止まらなくなり、時には命の危険さえ伴います。
3.生化学検査
(1)肝機能検査
AST(GOT)検査
ASTは心臓に最も多く含まれ,次いで肝臓、骨格筋などに存在します。この酵素は細胞の異常により血液中に流れ出るので、血液中の酵素量を測定して、心臓や、肝臓に障害が起こっているかどうかを知ることができます。
ALT(GPT)検査
肝臓の細胞中に最も多く含まれているので、特に肝機能検査を主な目的で行われる検査です。
γ-GTP検査
肝ー胆道系疾患のスクリーニング検査として用いられ、アルコール常習者などでは高値を示すことが多い。
ALP検査
肝臓から十二指腸に至る胆汁の流出経路に異常があるかどうかを知ることができる。骨の新生状況や肝機能、骨盤の機能が正常かどうかも分かります。 この他の肝機能検査としてビリルビン(Bil)、乳酸脱水素酵素(LDH)、アルブミン・グロブリン、コリンエステラーゼ(ChE)検査などがあります。
(2)腎臓検査
尿素窒素(BUN)とクレアチニン(Cr)
尿素は蛋白質代謝の終末産物で、クレアチンは、筋肉のエネルギー産生に関係するクレアチニン酸の代謝産物です。いずれも一種の老廃物であるから、腎臓の糸球体で濾過された後、尿中に排泄されます。排泄障害があると血液中に残り、血液中の濃度が高いと言うことは腎臓の障害が大きいということです。
(3)糖代謝検査
血糖検査(Glucose)
血液中のブドウ糖を血糖と呼びます。糖質をとると腸から吸収されて肝臓に運ばれ、グリコーゲンとして蓄えられていますが、必要に応じて再びブドウ糖となり血液の組織に運ばれます。膵臓から分泌するインスリンは糖代謝に強い関わりを持ち、インスリンの働きが弱いと血糖が高くなります。
グリコヘモグロビン検査(HbA1C)
グリコヘモグロビンは、赤血球に含まれる血色素のヘモグロビンとがブドウ糖が結合したものです。グリコヘモグロビンの濃度は過去1~3カ月間の平均的な血糖値を反映しているので、グリコヘモグロビンの量から過去のブドウ糖の濃度が推測できます。
(4)脂質検査
総コレステロール(CHO)検査
脂肪の消化を助ける胆汁酸、性ホルモンや副腎皮質ホルモンの合成材料であるばかりでなく、細胞膜の構成成分でもあり、人体になくてはならない物質である。低くすぎるとさまざまな障害を伴うことになり、多すぎると動脈硬化を促進させる一因ともなる。
HDLコレステロール検査(HDL-CHO)、LDLコレステロル検査(LDL-CHO))
血液中のコレステロールにはHDLコレステロール検査LDLコレステロル検査の2種類があり、前者を善玉コ レステロール、後者を悪玉コレステロールと呼ばれています。後者は動脈壁に蓄積する性質があり動脈硬化の一因 となるのに対し、前者は血管壁に付着した後者を積極的 に抜き取り排除する働きがあります。
中性脂肪(トリグリセライド、TG)
中性脂肪は体内にある脂肪の一種です。摂取された食物の中で、エネルギーとして使われなかった砂糖などの糖質や脂肪は、大部分皮下脂肪として蓄えられますが、そのほとんどが中性脂肪です。血中の中性脂肪濃 度が高いということは、肥満症や脂肪肝になりやすい。
上記以外にも、診断的意義のある生化学検査はたくさんあります。
外来診療のご案内
活動・取り組み
地域医療連携
研修医募集
採用情報
